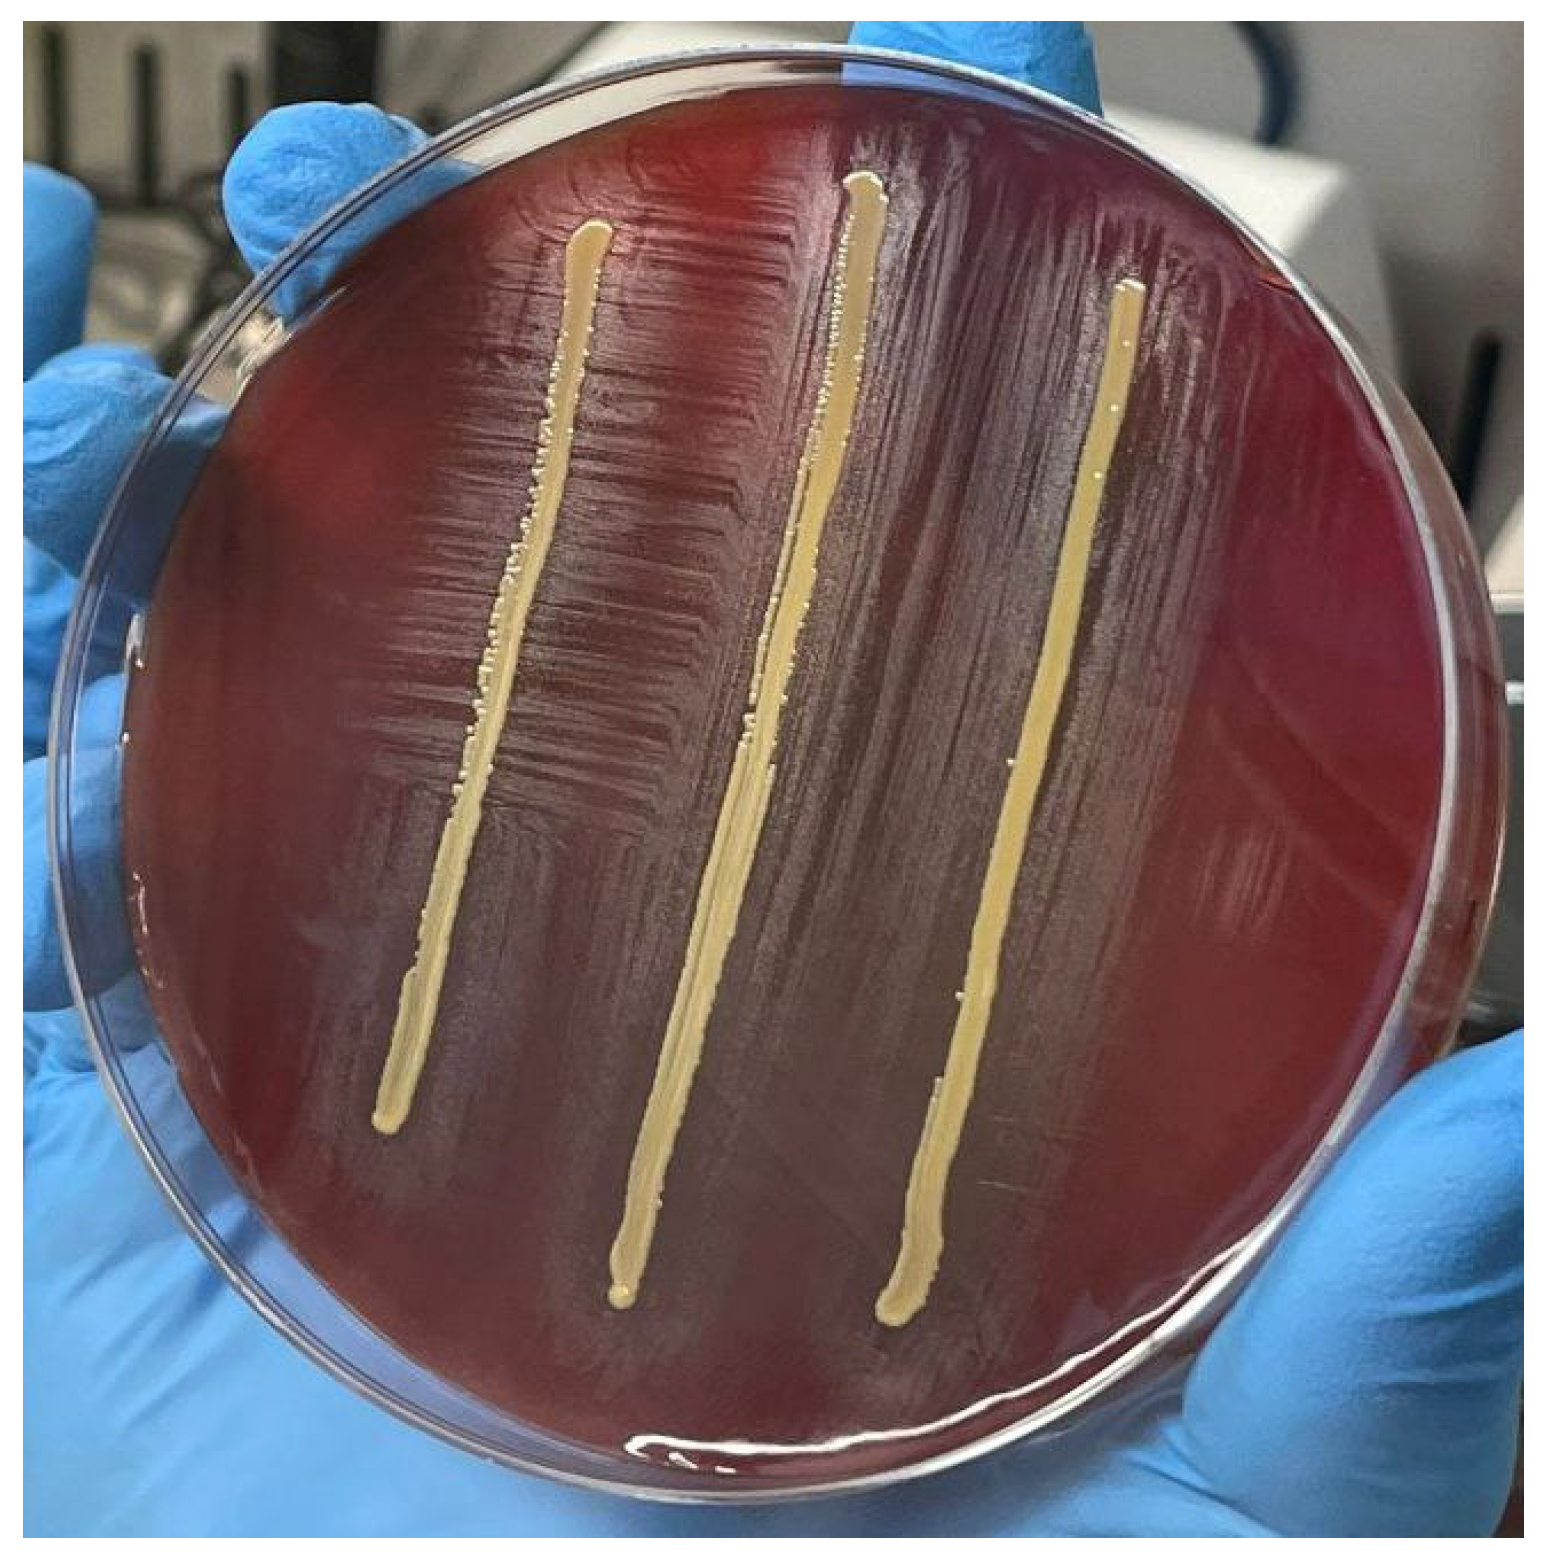
Idr 16 00020 g001

An Aminoglycoside-Sparing Regimen with Double Beta-Lactam to Successfully Treat Granulicatella adiacens Prosthetic Aortic Valve Endocarditis—Time to Change Paradigm?
Abstract
1. Introduction
2. Case Presentation
3. Laboratory Tests
4. Discussion
5. Conclusions
Author Contributions
Funding
Institutional Review Board Statement
Informed Consent Statement
Data Availability Statement
Conflicts of Interest
List of Abbreviations
| NVS | Nutritionally variant streptococci |
| IE | Infective endocarditis |
| NVE | Native valve endocarditis |
| PVE | Prosthetic valve endocarditis |
| AHA | American Heart Association |
| ESC | European Society of Cardiology |
| GL | Guidelines |
| PEN | Penicillin |
| AMP | Ampicillin |
| BRP | Ceftobiprole |
| CRO | Ceftriaxone |
| AML | Amoxicillin |
| CN | Gentamicin |
| AG | Aminoglycoside |
| PBPs | Penicillin-binding proteins |
| PM | Pacemaker |
| ED | Emergency department |
| CRP | C-reactive protein |
| CT | Computed tomography |
| TTE | Transthoracic echocardiography |
| MIC | Minimum inhibitory concentration |
| MBC | Minimum bactericidal concentration |
| MBIC | Minimum biofilm inhibitory concentration |
| BMD | Broth micro-dilution |
| FIC index | Fractional inhibitory concentration index |
| AST | Antimicrobial susceptibility testing |
| EFIE | Enterococcus faecalis infective endocarditis |
| CMHA | Chocolate Mueller Hinton Agar |
References
- Habib, G.; Erba, P.A.; Iung, B.; Donal, E.; Cosyns, B.; Laroche, C.; Popescu, B.A.; Prendergast, B.; Tornos, P.; Sadeghpour, A.; et al. Clinical presentation, aetiology and outcome of infective endocarditis. Results of the ESC-EORP EURO-ENDO (European infective endocarditis) registry: A prospective cohort study. Eur. Heart J. 2019, 40, 3222–3233. [Google Scholar] [CrossRef]
- Giuliano, S.; Caccese, R.; Carfagna, P.; Vena, A.; Falcone, M.; Venditti, M. Endocarditis caused by nutritionally variant streptococci: A case report and literature review. Infez. Med. 2012, 2, 67–74. [Google Scholar]
- Garibyan, V.; Shaw, D. Bivalvular endocarditis due to Granulicatella adiacens. Am. J. Case Rep. 2013, 14, 435–438. [Google Scholar] [PubMed]
- Shaik, A.; Roeuth, D.; Azmeen, A.; Thanikonda, V.; Guevara-Pineda, D.; Alamnajam, M.; Yamase, H.; Haider, L. Granulicatella Causing Infective Endocarditis and Glomerulonephritis. IDCases 2020, 21, e00792. [Google Scholar] [CrossRef] [PubMed]
- Baddour, L.M.; Wilson, W.R.; Bayer, A.S.; Fowler, V.G., Jr.; Tleyjeh, I.M.; Rybak, M.J.; Barsic, B.; Lockhart, P.B.; Gewitz, M.H.; Levison, M.E.; et al. Infective endocarditis in adults: Diagnosis, antimicrobial therapy, and management of complications. Circulation 2015, 132, 1435–1486. [Google Scholar] [CrossRef] [PubMed]
- ESC Scientific Document Group. 2023 ESC Guidelines for the management of endocarditis. Developed by the task force on the management of endocarditis of the European Society of Cardiology (ESC). Endorsed by the European Association for Cardio-Thoracic Surgery (EACTS) and the European Association of Nuclear Medicine (EANM). Eur. Heart J. 2023, 44, 3948–4042. [Google Scholar] [CrossRef]
- Khan, S.; Urban, C.; Singh, V.; Liu, D.; Segal-Maurer, S.; Parmar, Y.; Yoon, J. Novel double beta-lactam therapy for Granulicatella adiacens infective endocarditis. IDCases 2021, 24, e01082. [Google Scholar] [CrossRef] [PubMed]
- Muyzer, G.; De Waal, E.C.; Uitterlinden, A.G. Profiling of Complex Microbial Populations by Denaturing Gradient Gel Electrophoresis Analysis of Polymerase Chain Reaction-Amplified Genes Coding for 16S rRNA. Appl. Environ. Microbiol. 1993, 59, 695–700. [Google Scholar] [CrossRef] [PubMed]
- White, R.L.; Burgess, D.S.; Manduru, M.; Bosso, J.A. Comparison of three different in vitro methods of detecting synergy: Time-kill, checkerboard, and E test. Antimicrob. Agents Chemother. 1996, 40, 1914–1918. [Google Scholar] [CrossRef]
- Alberti, M.O.; Hindler, J.A.; Humphries, R.M. Antimicrobial Susceptibilities of Abiotrophia defectiva, Granulicatella adiacens, and Granulicatella elegans. Antimicrob. Agents Chemother. 2016, 60, 1411–1420. [Google Scholar] [CrossRef]
- Mushtaq, A.; Greenwood-Quaintance, K.E.; Cole, N.C.; Kohner, P.C.; Ihde, S.M.; Strand, G.J.; Harper, L.W.; Virk, A.; Patel, R. Differential antimicrobial susceptibilities of Granulicatella adiacens and Abiotrophia defectiva. Antimicrob. Agents Chemother. 2016, 60, 5036–5039. [Google Scholar] [CrossRef]
- Kanamoto, T.; Terakubo, S.; Nakashima, H. Antimicrobial Susceptibilities of Oral Isolates of Abiotrophia and Granulicatella According to the Consensus Guidelines for Fastidious Bacteria. Medicines 2018, 5, 129. [Google Scholar] [CrossRef] [PubMed]
- Podgórska, A.; Kordybach-Prokopiuk, M.; Jaworska-Wilczyńska, M.; Hoffman, P.; Biernacka, K.; Kuśmierski, K.; Kuthan, R.; Hryniewiecki, T.; Lutyńska, A. The First Case of Granulicatella adiacens Identified from a Resected Heart Valve by Next Generation Sequencing (NGS) in Poland. Pathogens 2022, 11, 295. [Google Scholar] [CrossRef] [PubMed]
- Bouvet, A. Human endocarditis due to nutritionally variant streptococci: Streptococcus adjacens and Streptococus defectivus. Eur. Heart J. 1995, 16, 24–27. [Google Scholar] [CrossRef] [PubMed]
- Di Domenico, E.G.; Rimoldi, S.G.; Cavallo, I.; D’Agosto, G.; Trento, E.; Cagnoni, G.; Palazzin, A.; Pagani, C.; Romeri, F.; De Vecchi, E.; et al. Microbial biofilm correlates with an increased antibiotic tolerance and poor therapeutic outcome in infective endocarditis. BMC Microbiol. 2019, 19, 228. [Google Scholar] [CrossRef]
- Flateau, C.; Riazi, A.; Cassard, B.; Camus, M.; Diamantis, S. Streptococcal and enterococcal endocarditis: Time for individualized antibiotherapy? J. Antimicrob. Chemother. 2021, 76, 3073–3076. [Google Scholar] [CrossRef]
- Lalanne, S.; Guérin, F.; Flécher, E.; Cattoir, V.; Nesseler, N.; Revest, M.; Verdier, M.-C. Diffusion of amoxicillin into heart valves from infective endocarditis patients. J. Antimicrob. Chemother. 2023, 78, 232–237. [Google Scholar] [CrossRef]
- Martin, C.; Viviand, X.; Alaya, M.; Lokiec, F.; Ennabli, K.; Said, R.; Pecking, M. Penetration of ceftriaxone (1 or 2 grams intravenously) into mediastinal and cardiac tissues in humans. Antimicrob. Agents Chemother. 1996, 40, 812–815. [Google Scholar] [CrossRef]
- Tattevin, P.; Tribut, O.; Arvieux, C.; Dupont, M.; Flicoteaux, R.; Desbordes, L.; Le Tulzo, Y.; Michelet, C. Use of high-performance liquid chromatography (HPLC) to monitor beta-lactam plasma concentrations during the treatment of endocarditis. Clin. Microbiol. Infect. 2005, 11, 76–79. [Google Scholar] [CrossRef]
- Giuliano, S.; Angelini, J.; Flammini, S.; Tascini, C. Comment on: Streptococcal and enterococcal endocarditis: Time for individualized antibiotherapy? J. Antimicrob. Chemother. 2022, 77, 2044–2045. [Google Scholar] [CrossRef]
- Weber, C.; Petrov, G.; Luehr, M.; Aubin, H.; Tugtekin, S.M.; Borger, M.A.; Akhyari, P.; Wahlers, T.; Hagl, C.; Matschke, K.; et al. Surgical results for prosthetic versus native valve endocarditis: A multicenter analysis. J. Thorac. Cardiovasc. Surg. 2021, 161, 609–619. [Google Scholar] [CrossRef]
- Gould, F.K.; Denning, D.W.; Elliott, T.S.; Foweraker, J.; Perry, J.D.; Prendergast, B.D.; Sandoe, J.A.; Spry, M.J.; Watkin, R.W.; Working Party of the British Society for Antimicrobial Chemotherapy. Guidelines for the diagnosis and antibiotic treatment of endocarditis in adults: A report of the Working Party of the British Society for Antimicrobial Chemotherapy. J. Antimicrob. Chemother. 2012, 67, 269–289. [Google Scholar] [CrossRef]
- Sinner, S.W.; Tunkel, A.R. Viridans Streptococci, Nutritionally Variant Streptococci, Groups C and G Streptococci, and Other Related Organisms. In Mandell, Douglas, and Bennett’s Principles and Practice of Infectious Diseases, 8th ed.; WB Saunders: Philadelphia, PA, USA, 2015. [Google Scholar]
- Shailaja, T.S.; Sathiavathy, K.A.; Unni, G. Infective endocarditis caused by Granulicatella adiacens. Indian Heart J. 2013, 65, 447–449. [Google Scholar] [CrossRef]
- Mainardi, J.L.; Gutmann, L.; Acar, J.F.; Goldstein, F.W. Synergistic effect of amoxicillin and cefotaxime against Enterococcus faecalis. Antimicrob. Agents Chemother. 1995, 39, 1984–1987. [Google Scholar] [CrossRef] [PubMed]
- Marino, A.; Munafò, A.; Zagami, A.; Ceccarelli, M.; Di Mauro, R.; Cantarella, G.; Bernardini, R.; Nunnari, G.; Cacopardo, B. Ampicillin Plus Ceftriaxone Regimen against Enterococcus faecalis Endocarditis: A Literature Review. J. Clin. Med. 2021, 10, 4594. [Google Scholar] [CrossRef] [PubMed]
- Giuliano, S.; Angelini, J.; D’Elia, D.; Geminiani, M.; Barison, R.D.; Giacinta, A.; Sartor, A.; Campanile, F.; Curcio, F.; Cotta, M.O.; et al. Ampicillin and Ceftobiprole Combination for the Treatment of Enterococcus faecalis Invasive Infections: “The Times They Are A-Changin”. Antibiotics 2023, 12, 879. [Google Scholar] [CrossRef] [PubMed]
- Pilmis, B.; Lourtet-Hascoët, J.; Barraud, O.; Piau, C.; Isnard, C.; Hery-Arnaud, G.; Amara, M.; Merens, A.; Farfour, E.; Thomas, E.; et al. Be careful about MICs to amoxicillin for patients with Streptococci-related infective endocarditis. Int. J. Antimicrob. Agents 2019, 53, 850–854. [Google Scholar] [CrossRef] [PubMed]
- Van der Meer, J.T.M.; Van Vianen, W.; Hu, E.; Van Leeuwen, W.B.; Valkenburg, H.A.; Thompson, J.; Michel, M.F. Distribution, antibiotic susceptibility and tolerance of bacterial isolates in culture-positive cases of endocarditis in The Netherlands. Eur. J. Clin. Microbiol. Infect. Dis. 1991, 10, 728–734. [Google Scholar] [CrossRef] [PubMed]
- Lebeaux, D.; Fernández-Hidalgo, N.; Pilmis, B.; Tattevin, P.; Mainardi, J.L. Aminoglycosides for infective endocarditis: Time to say goodbye? Clin. Microbiol. Infect. 2020, 26, 723–728. [Google Scholar] [CrossRef] [PubMed]
- Clinical and Laboratory Standards Institute (CLSI). Methods for Antimicrobial Dilution and Disk Susceptibility Testing of Infrequently Isolated or Fastidious Bacteria, 3rd ed.; CLSI Guideline M45; Clinical and Laboratory Standards Institute: Wayne, PA, USA, 2015. [Google Scholar]
- Alberti, M.O.; Hindler, J.A.; Humphries, R.M. Comparison of Antimicrobial Susceptibility Testing by Broth Microdilution and E-Test for Abiotrophia defectiva and Granulicatella spp. Am. J. Clin. Pathol. 2015, 143, A035. [Google Scholar] [CrossRef]
- Alberti, M.O.; Hindler, J.A.; Humphries, R.M. Performance of Etest for Antimicrobial Susceptibility Testing of Abiotrophia defectiva and Granulicatella Species. J. Clin. Microbiol. 2016, 54, 2194–2196. [Google Scholar] [CrossRef] [PubMed][Green Version]
- Cañas, M.A.; Téllez, A.; García de la Mària, C.; Dahl, A.; García-González, J.; Hernández-Meneses, M.; Almela, M.; Ambrosioni, J.; Falces, C.; Quintana, E.; et al. Development of High-Level Daptomycin Resistance in Abiotrophia and Granulicatella Species Isolates from Patients with Infective Endocarditis. Antimicrob. Agents Chemother. 2021, 65, e02522-20. [Google Scholar] [CrossRef] [PubMed]

| PEN | AMP | AML | BPR | CPT | CRO | CTX | IMI | LNZ | CN | STR | TEI | VAN | DAP | TGC | DAL | |
|---|---|---|---|---|---|---|---|---|---|---|---|---|---|---|---|---|
| NS | NS | S | NA | NA | R | R | S | NA | NA | NA | NA | S | NA | NA | NA | |
| Granulicatella | 0.5 | 0.5 | 0.125 | 0.19 | 2 | 32 | 8 | 0.25 | 2 | 4 | 1 | 1 | 1 | 4 * | 0.094 | 0.125 |
| DRUG A | DRUG B | MIC Drug A | MIC Drug B | MIC Drug A in Combination | MIC Drug B in Combination | FIC Drug A | FIC Drug B | FIC Index | INTERPRETATION |
|---|---|---|---|---|---|---|---|---|---|
| AMP 1× | BPR 1× | 0.5 | 0.19 | 0.125 | 0.047 | 0.25 | 0.247 | 0.49 | SYN |
| AMP 1× | BPR 2× | 0.5 | 0.38 | 0.125 | 0.023 | 0.25 | 0.06 | 0.31 | SYN |
| AMP 1× | CRO 1× | 0.5 | 32 | 0.094 | 2 | 0.188 | 0.062 | 0.25 | SYN |
| AMP 1× | CRO 2× | 0.5 | 64 | 0.047 | 8 | 0.094 | 0.125 | 0.21 | SYN |
| AMP 1× | CN 1× | 0.5 | 4 | 0.25 | 3 | 0.5 | 0.75 | 1.25 | IND |
| AMP 2× | CN 1× | 1 | 4 | 0.25 | 0.75 | 0.25 | 0.188 | 0.4 | SYN |
| BPR 1× | CN 1× | 0.19 | 4 | 0.125 | 3 | 0.658 | 0.75 | 1.4 | IND |
| BPR 2× | CN 1× | 0.38 | 4 | 0.094 | 1 | 0.247 | 0.25 | 0.4 | SYN |
| CRO 1× | CN 1× | 32 | 4 | 16 | 2 | 0.5 | 0.5 | 1 | ADD |
| CRO 2× | CN 1× | 64 | 4 | 4 | 0.75 | 0.0625 | 0.187 | 0.25 | SYN |
Disclaimer/Publisher’s Note: The statements, opinions and data contained in all publications are solely those of the individual author(s) and contributor(s) and not of MDPI and/or the editor(s). MDPI and/or the editor(s) disclaim responsibility for any injury to people or property resulting from any ideas, methods, instructions or products referred to in the content. |
© 2024 by the authors. Licensee MDPI, Basel, Switzerland. This article is an open access article distributed under the terms and conditions of the Creative Commons Attribution (CC BY) license (https://creativecommons.org/licenses/by/4.0/).
Share and Cite
Pagotto, A.; Campanile, F.; Conti, P.; Prataviera, F.; Della Siega, P.; Flammini, S.; Giuliano, S.; Martini, L.; Pecori, D.; Sartor, A.; et al. An Aminoglycoside-Sparing Regimen with Double Beta-Lactam to Successfully Treat Granulicatella adiacens Prosthetic Aortic Valve Endocarditis—Time to Change Paradigm? Infect. Dis. Rep. 2024, 16, 249-259. https://doi.org/10.3390/idr16020020
Pagotto A, Campanile F, Conti P, Prataviera F, Della Siega P, Flammini S, Giuliano S, Martini L, Pecori D, Sartor A, et al. An Aminoglycoside-Sparing Regimen with Double Beta-Lactam to Successfully Treat Granulicatella adiacens Prosthetic Aortic Valve Endocarditis—Time to Change Paradigm? Infectious Disease Reports. 2024; 16(2):249-259. https://doi.org/10.3390/idr16020020
Chicago/Turabian StylePagotto, Alberto, Floriana Campanile, Paola Conti, Francesca Prataviera, Paola Della Siega, Sarah Flammini, Simone Giuliano, Luca Martini, Davide Pecori, Assunta Sartor, and et al. 2024. "An Aminoglycoside-Sparing Regimen with Double Beta-Lactam to Successfully Treat Granulicatella adiacens Prosthetic Aortic Valve Endocarditis—Time to Change Paradigm?" Infectious Disease Reports 16, no. 2: 249-259. https://doi.org/10.3390/idr16020020
APA StylePagotto, A., Campanile, F., Conti, P., Prataviera, F., Della Siega, P., Flammini, S., Giuliano, S., Martini, L., Pecori, D., Sartor, A., Screm, M., Semenzin, T., & Tascini, C. (2024). An Aminoglycoside-Sparing Regimen with Double Beta-Lactam to Successfully Treat Granulicatella adiacens Prosthetic Aortic Valve Endocarditis—Time to Change Paradigm? Infectious Disease Reports, 16(2), 249-259. https://doi.org/10.3390/idr16020020

